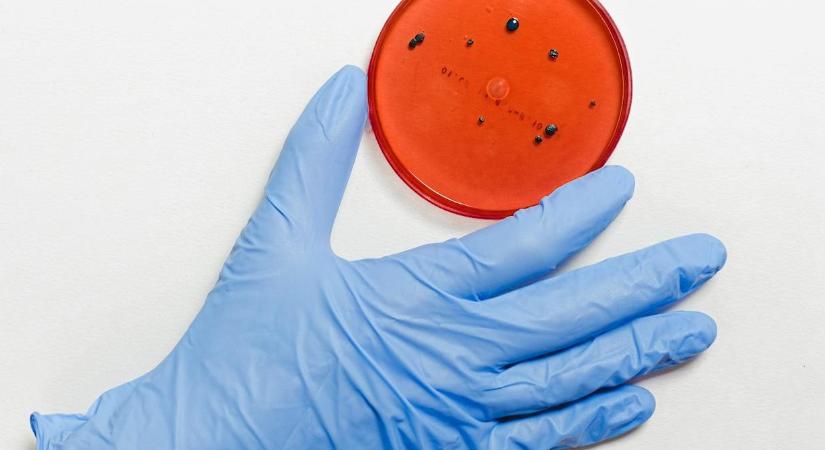

12 millió baktérium él azon a tárgyon, amit minden nap a szánkba teszünk
Tudjuk, hogy milliónyi baktérium él a környzetünkben, de hogy éppen egy higiéniai ezköz lenne a legfertőzöttebb, abba nem jó belegondolni.
Hamarosan átirányítunk a teljes cikkhez → 168.hu